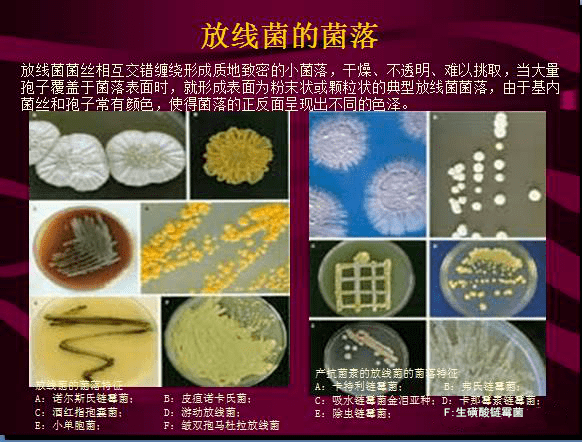
常见微生物菌落形态及消毒灭菌方式大汇总

菌落识别图

图1 病原菌的菌落形态a. pda培养基;b.
图片尺寸1878x1420
干货|各种微生物菌落图,您都分得清吗?
图片尺寸601x1404
霉菌分类之菌落观察——超清的菌落照片(答案在p7)
图片尺寸950x605
微生物菌落形态特征辨别
图片尺寸1840x3264
微生物菌落征形态等总结大全(表格带图片).doc
图片尺寸792x1120
各种微生物形成的菌落特征
图片尺寸1080x810
微生物菌落特征形态等总结大全(表格带图片)
图片尺寸769x942
菌落形态问题
图片尺寸532x310
一张图告诉你真菌孢子的多样性 1-2:不认识,大概
图片尺寸960x1280
(肉眼可见,菌落总数在储存12小时和24小时后逐渐递增,在24小时候菌落
图片尺寸600x450
全自动数菌落你觉得数的准吗
图片尺寸1080x810
各种微生物菌落图您都分得清吗
图片尺寸590x782
【资料】常见微生物菌落形态
图片尺寸499x370
微生物菌落征形态等总结大全(表格带图片).doc
图片尺寸792x1120
各种微生物菌落图您都分得清吗
图片尺寸586x745
常见微生物菌落形态及消毒灭菌方式大汇总
图片尺寸582x442
我想看菌落群总数和大肠菌流程图片
图片尺寸3669x2452
【专题】各种念珠菌菌落形态图片欣赏
图片尺寸3264x1952
微生物学实验三ppt 光滑型(s型) 粗造型(r型) 粘液型(m型) 菌落(s型)
图片尺寸1080x810
关于菌落总数检测问题求助
图片尺寸1080x1440